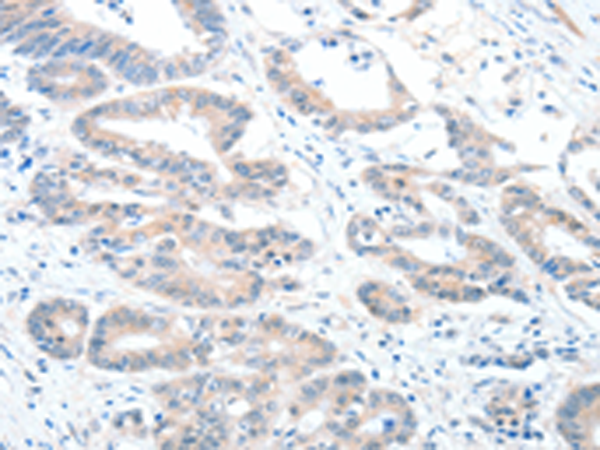

-
分类: 科研抗体货号: P11439别名: RALDH2; RALDH2-T; RALDH(II)应用: WB,IHC反应种属: Human, Mouse, Rat
-
分类: 科研抗体货号: P11437别名: AAT1; ALT1; GPT1应用: IHC反应种属: Human, Mouse, Rat
-
分类: 科研抗体货号: P11456别名: DCP; ICH; ACE1; DCP1; CD143; MVCD3应用: WB,IHC反应种属: Human, Mouse, Rat
-
分类: 科研抗体货号: P11436别名: MPPH; PKBG; PRKBG; STK-2; PKB-GAMMA; RAC-gamma; RAC-PK-gamma应用: IHC反应种属: Human, Mouse, Rat
-
分类: 科研抗体货号: P11472别名: p200; BAF200应用: WB,IHC反应种属: Human, Mouse
-
分类: 科研抗体货号: P11455别名: AGP4; ANG4; ANG-3应用: WB,IHC反应种属: Human
-
分类: 科研抗体货号: P11465别名: A3C; PBI; ARP5; ARDC2; ARDC4; APOBEC1L; bK150C2.3应用: WB反应种属: Human
-
分类: 科研抗体货号: P11470别名: INT1; OI15; BMND16应用: WB,IHC反应种属: Human, Mouse
-
分类: 科研抗体货号: P11452别名: MAD; MADA应用: WB,IHC反应种属: Human
-
分类: 科研抗体货号: P11464别名: ARP1; ARCD1应用: WB反应种属: Human, Mouse

鄂公网安备42018502007531号
鄂公网安备42018502007531号

